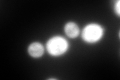
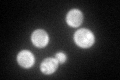

View description
Cytoplasmic and mitochondrial glycyl-tRNA synthase that ligates glycine to the cognate anticodon bearing tRNA; transcription termination factor that may interact with the 3'-end of pre-mRNA to promote 3'-end formation
Localization:
Intensity:
Fold change:
Significance:
-
C’ GFP library in SD

cytosol323.68 -
N' NOP1pr-GFP in SD

cytosol287.576 -
N' TEF2pr-mCherry in SD

missing0 -
N' NATIVEpr-GFP in SD

below threshold17.859 -
N' TEF2pr-VC and Cyto-VN in SD

#N/A0 -
C’ GFP library in SD+DTT
cytosol403.251.24No -
C’ GFP library in SD+H2O2

cytosol386.311.19No -
C’ GFP library in Starvation Media
cytosol233.30.72No -
C’ GFP library on the background of Pup2-DaMP

cytosol -
C’ GFP library on the background of CCT mutant

cytosol403.051.24518No
